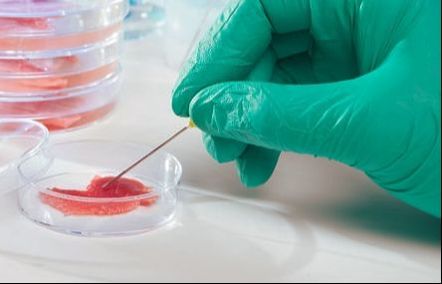
cellular agriculture

Technologies for a Changing World
Cellular agriculture: Can advances in technology make this a viable option for meat production in the future? Will insects be the next source of protein?
Event Speakers
- Dr. Sudip Rakshit, Biorefining Research Institute, Lakehead University
- Dr. Michael Campbell, Physics, Lakehead University
- Dr. Baoqiang Liao, Chemical Engineering, Lakehead University
- Dr. Charles Levkoe, Health Sciences, Lakehead University